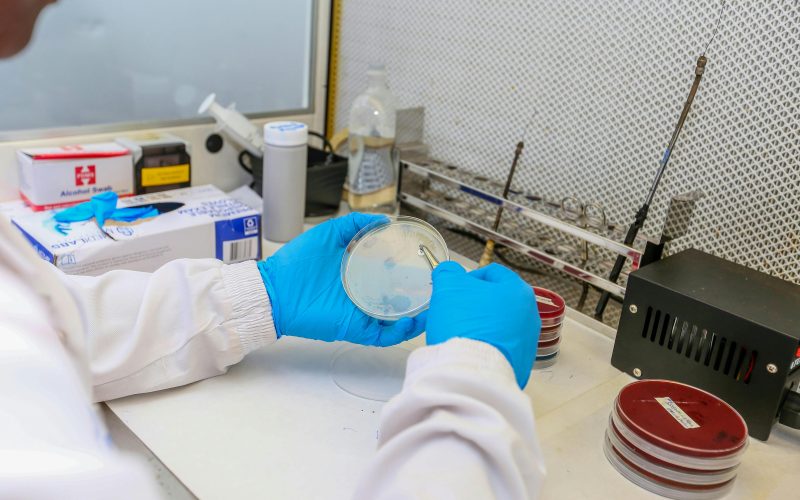
CAPA-IVM, o metoda utila in reducerea dependentei de injectii hormonale in timpul tratamentelor de fertilizare in vitro

PRIMUL TRIMESTRU DE SARCINA
AL DOILEA TRIMESTRU DE SARCINA
AL TREILEA TRIMESTRU DE SARCINA
Totul despre Sarcina
Nasterea
Fertilitatea
CAPA-IVM, o metoda utila in reducerea dependentei de injectii hormonale in timpul tratamentelor de fertilizare in vitro
Alimentatia gravidei
Spanacul în sarcină: Beneficii uimitoare, riscuri și cele mai bune moduri de preparare
Carnea de strut in alimentatia gravidei. Poate fi consumata in siguranta si ce beneficii are?
Ingrijirea bebelusului
Cele mai recente articole
CAPA-IVM, o metoda utila in reducerea dependentei de injectii hormonale in timpul tratamentelor de fertilizare in vitro
Marea problema cu fertilizarea in vitro este legata de injectiile hormonale repetate pe o perioada lunga de timp si de timpii de asteptare prea mari....
Sexul dupa nastere. Cat de diferit se simte din perspectiva femeii si a partenerului sexual?
Sexul dupa nastere se simte adesea diferit din cauza schimbarilor hormonale, a vindecarii si a ajustarilor fizice, rezultand frecvent uscaciune, sensibilitate redusa sau durere initial,...
Plagiocefalia (sindromul capului turtit). Preventie acasa si diagnosticare corecta
Inca din primele saptamani de viata cei mici incep sa se confrunte cu tot felul de probleme. O problema de sanatate frecventa e si plagiocefalia...
Uterul didelfic, defectul congenital care poate aduce complicatii la nasterea vaginala
In teorie, nasterea este un proces care „merge de la sine”. Incep contractiile puternice, la intervale regulate, fatul se deplaseaza pe o cale deja stabilita,...
Spanacul în sarcină: Beneficii uimitoare, riscuri și cele mai bune moduri de preparare
Daca esti gravida si vrei sa consumi ceva usor si plin de nutrienti, vitamine, minerale, care sa te ajute si pe tine, dar si pe...
Ptyalism gravidarum sau productia excesiva de saliva in sarcina
Sarcina e o perioada de incercare pentru femei. In cele noua luni de sarcina apar atat de multe afectiuni de care nici nu stiai si...